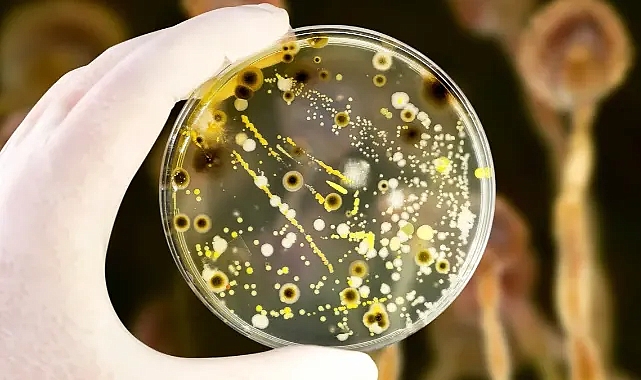

(LONDRA) – Bilim dünyası, laboratuvarlarda geliştirilen yeni bir yaşam formunun insanlık için “geri dönüşü olmayan bir tehlike” yaratabileceği uyarısında bulundu. “Aynalı bakteriler” olarak adlandırılan bu yapay mikroplar, doğadaki moleküler düzenin tam tersine tasarlanıyor ve bu sayede hiçbir bağışıklık sistemi tarafından tanınmıyor.
Science dergisinde yayımlanan makalede, iki Nobel ödüllü bilim insanının da aralarında bulunduğu uluslararası bir ekip, bu bakterilerin “doğal savunma sistemlerini devre dışı bırakabileceğini” belirtti. Raporda, “Eğer laboratuvardan sızarlarsa, insan, hayvan ve bitki yaşamı hiçbir koruma geliştiremez” denildi.
Yaşamın aynadaki kopyası
Doğadaki tüm canlılar, sağ el yönelimli moleküllerle inşa edilirken, aynalı bakteriler bu düzenin tam tersine — sol el yönelimli — moleküllerden oluşuyor.
Pittsburgh Üniversitesi’nden Prof. Vaughn Cooper, bu farkın ölümcül olabileceğini söylüyor: “Bağışıklık sistemi onları tanıyamaz. Bu da enfeksiyonların önlenemez şekilde yayılması anlamına gelir.”
Kontrolden çıkan deney uyarısı
Uzmanlara göre böyle bir mikrop, yanlışlıkla doğaya karışırsa küresel bir biyolojik felakete yol açabilir. Raporda, “Bu mikroplar ekosistemi çökertir, gıda zincirini durdurur, yaşamın temellerini yok eder” ifadeleri yer aldı. Henüz bu tür bakteriler üretilmemiş olsa da genetik mühendisliğin geldiği nokta, riskin giderek arttığını gösteriyor.
Bilim kurgu değil, gerçek bir kabus ihtimali
Harvard Üniversitesi Wyss Enstitüsü’nden araştırmacılar, bu olasılığın “bilim kurgu değil, bilimsel bir uyarı” olduğunu vurguladı. Uzmanlar, tüm genetik deneylerin uluslararası etik denetime alınmasını ve laboratuvar güvenliği protokollerinin yeniden tanımlanmasını öneriyor.
Bilim dünyasında ise tek soru yankılanıyor: İnsanlık, kendi yarattığı mikroptan kaçabilecek mi?
Kaynak: Haber Merkezi